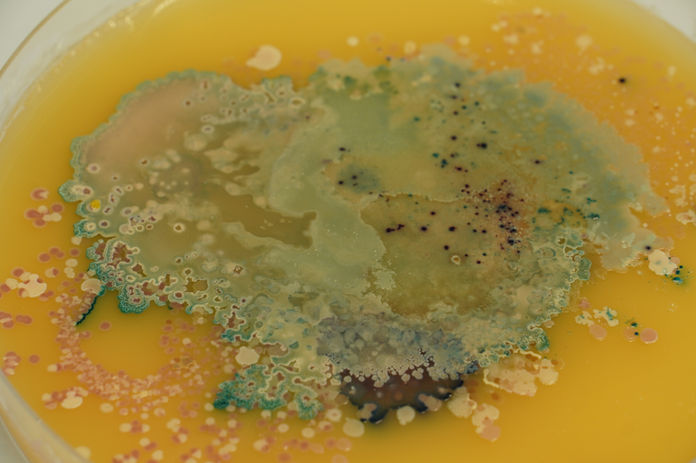

"This sculpture, made from a cast of the artist’s face, is a living artwork; the bacteria from her skin grow and mix with the colonies of microbes present in the environment. It grows and dies, reflecting the cycle of life. It explores the relationship between us human beings and our microbiota." - The Eden Project
Microbial Me brings the invisible world of bacteria through visual art, showcasing the ecosystems on our skin through a series of agar sculptures displaying bacteria. By casting her own face and swabbing the bacteria Monsoon encourages viewers to reflect on the microorganisms present on their own skin.
In 2015, Monsoon was commissioned by the Eden Project to create Microbial Me for the exhibition Invisible: You The Human Microbiome. The sculpture is on permanent display and has been living in the exhibition for almost 10 years.
In 2017, Monsoon was commissioned by the BBC to create a full body cast of TV presenter Michael Mosley, for project Microbial Michael. As a giant experiment to explore various aspects of antimicrobial resistance, this enabled both artist and scientist to see what difference antibiotics make to our natural flora and how quickly we can come resistant.
In 2023, Monsoon was commissioned to create Microbial Me at the Institute of Microbiology in CHUV, in preparation for the 2 year exhibition Invisible: The Hidden Life Of Microbes, at the Musée De La Main in Lausanne, Switzerland.
MICROBIAL ME
Invisible. The Hidden Life of Microbes
Musee De La Main, Lausanne, Switzerland
Experiments at the Institute of Microbiology
THE EDEN PROJECT
INVISIBLE YOU: THE HUMAN MICROBIOME






































First Exhibition of 'Microbial Me' - Microbiological Portraits - Face of Truth - Broad Vision 2013, GV Art
In collaboration with: Professor Mark Clements, Kitti Edwards & Frederick Bell
Microbial Me was first created in 2013 during an Art & Science collaboration module called Broad Vision at the University of Westminster, where Monsoon collaborated with students from courses such as Psychology, Life Sciences, Illustration, Photography and Imaging Science. Each year, students were to collaborate with different disciplines on a theme in science.
During her introduction to Life Sciences, Monsoon took a particular liking and curiosity to bacteria, and, using agar as a sculpting medium and swabs of bacteria from the surface of her skin, she created a living sculpture that changes and evolves over time.
Microbial Me is in collaboration with Professor Mark Clements & Dr Richard Harvey and supported by ThermoFisher Scientific.
Whilst Monsoon studied her MA in Art & Science at Central Saint Martins (2014-16), she continued her collaboration with agar and bacteria and experimented with sculpture and casting other body parts; works such as Lady MYcrobiome and Microbial Femunculus
Microbial Me: 2013